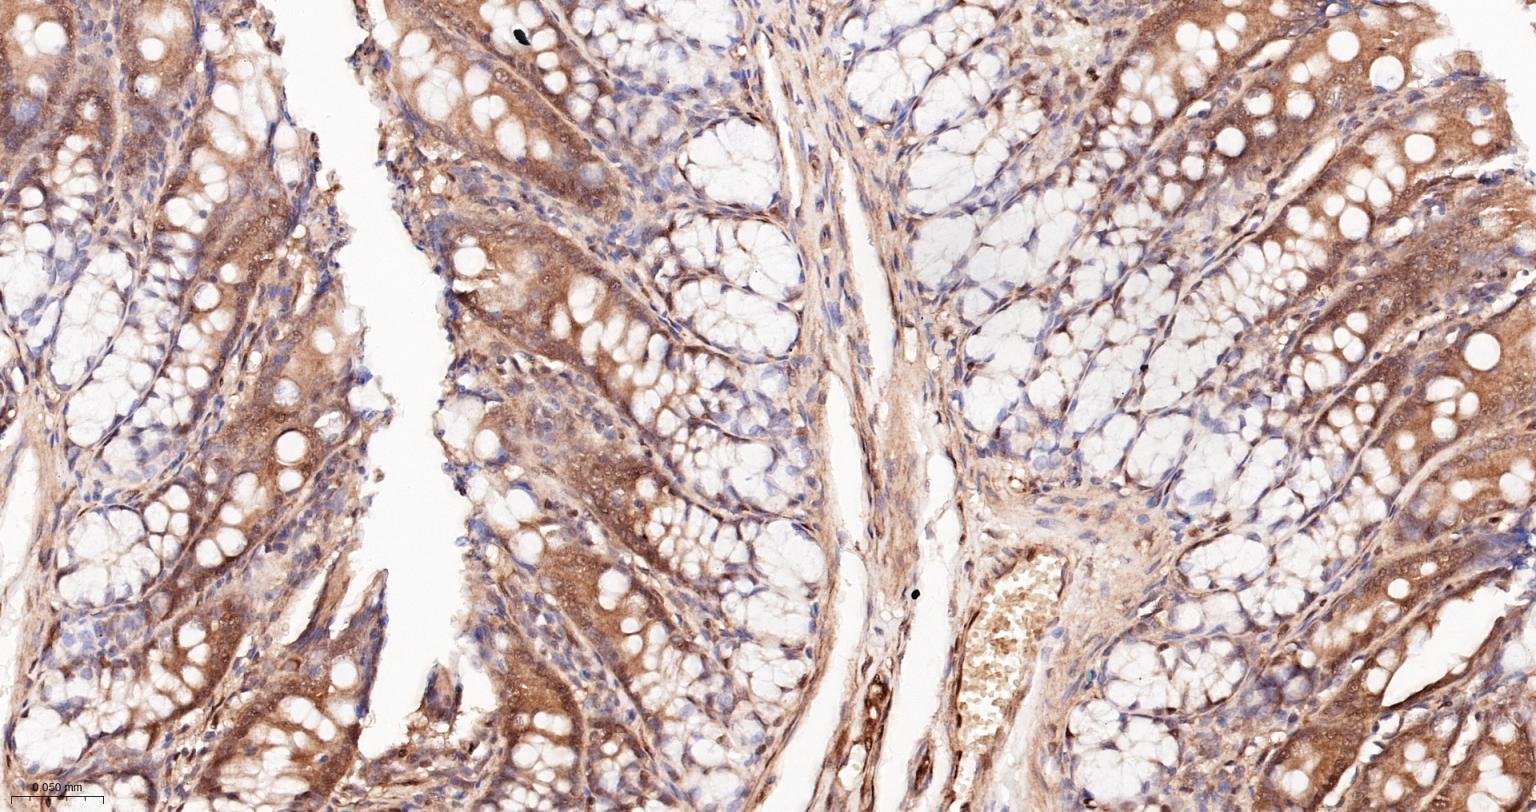
泛素蛋白重组兔单抗
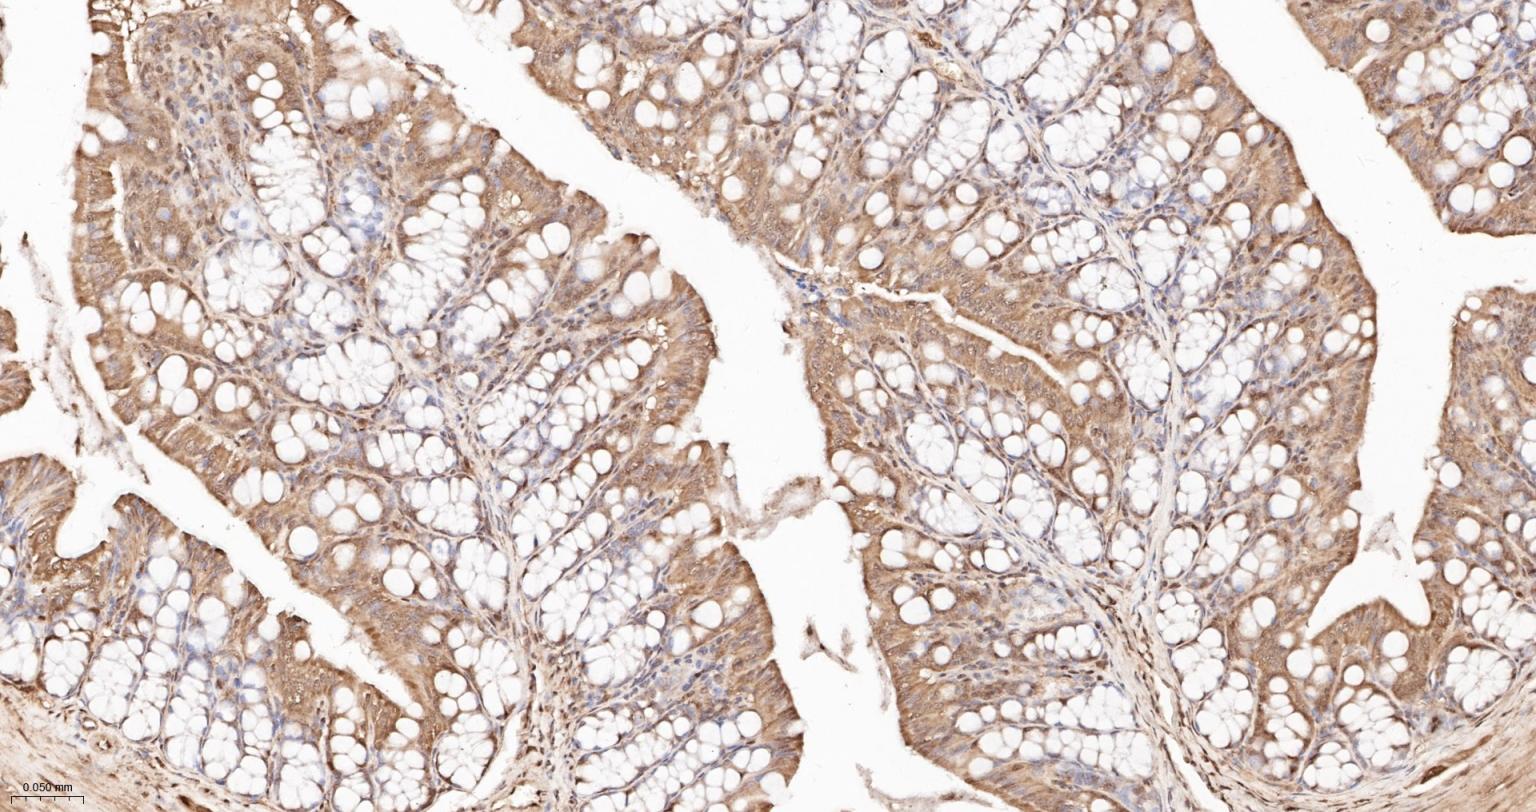
泛素蛋白重组兔单抗

泛素蛋白重组兔单抗
Rrmab?兔单抗

货号:bsm-63008R
产品详情
相关标记
相关产品
相关文献
常见问题
概述
产品编号
bsm-63008R
产品类型
重组兔单抗、mIHC精品抗体
英文名称
Ubiquitin Recombinant Rabbit mAb
中文名称
泛素蛋白重组兔单抗
英文别名
HEL-S-50; Rps27a; Uba52; Ubb2; Ubc; UBB_BOVIN; UBB; UBB_HORSE; UBB_HUMAN; UBC_HUMAN; UBIQ_HUMAN; UBB_MOUSE; UBIQ_MOUSE; UBB_RAT; UBIQ_RAT;
抗体来源
Rabbit
免疫原
A synthesized peptide derived from human Ubiquitin: 50-76
亚型
IgG
性状
Liquid
纯化方法
affinity purified by Protein A
克隆类型
Recombinant
克隆号
19D17
理论分子量
26 kDa
检测分子量
26 kDa
储存液
10mM phosphate buffered saline(pH 7.4) with 150mM sodium chloride, 0.05% BSA, 0.02% Proclin300 and 50% glycerol.
研究领域
SWISS
Gene ID
保存条件
Store at 4℃ for short term. Store at -20℃ for long term. Avoid repeated freeze/thaw cycles.
注意事项
This product as supplied is intended for research use only, not for use in human, therapeutic or diagnostic applications.
数据库链接
产品介绍
泛素及类泛素蛋白(Ubls) 存在在多种细胞中,有多种细胞调控的功能,如细胞增殖、凋亡、细胞周期及DNA修复等。但泛素途径的异常会导致人类疾病的产生,包括多种形式的肿瘤的发生,神经退变等都与泛素有关。
相关产品:
Ubiquitin 1-76 peptides (bs-10803P);
相关产品:
Ubiquitin 1-76 peptides (bs-10803P);
背景资料
Ubiquitin: Exists either covalently attached to another protein, or free (unanchored). When covalently bound, it is conjugated to target proteins via an isopeptide bond either as a monomer (monoubiquitin), a polymer linked via different Lys residues of the ubiquitin (polyubiquitin chains) or a linear polymer linked via the initiator Met of the ubiquitin (linear polyubiquitin chains).

产品应用
| 应用 | 已检合格种属 | 预测种属 | 推荐稀释比例 |
|---|---|---|---|
| WB | Human | Mouse, Rat | 1:500-2000 |
| IHC-P | Human, Mouse, Rat | 1:100-500 | |
| IHC-F | Human, Mouse, Rat | 1:100-500 | |
| IF | Human, Mouse, Rat | 1:100-500 | |
| Flow-Cyt | Human | Mouse, Rat | 1:50-100 |
| ICC/IF | Human, Mouse, Rat | 1:50-200 |
交叉反应
交叉反应: Human, Mouse, Rat
相关产品
暂无相关产品
靶标
基因名
UBB
蛋白名
Polyubiquitin-B
亚细胞定位
Cytoplasm. Nucleus.
相似性
Belongs to the ubiquitin family.
Contains 9 ubiquitin-like domains.
Contains 9 ubiquitin-like domains.
功能
Ubiquitin exists either covalently attached to another protein, or free (unanchored). When covalently bound, it is conjugated to target proteins via an isopeptide bond either as a monomer (monoubiquitin), a polymer linked via different Lys residues of the ubiquitin (polyubiquitin chains) or a linear polymer linked via the initiator Met of the ubiquitin (linear polyubiquitin chains). Polyubiquitin chains, when attached to a target protein, have different functions depending on the Lys residue of the ubiquitin that is linked: Lys-6-linked may be involved in DNA repair; Lys-11-linked is involved in ERAD (endoplasmic reticulum-associated degradation) and in cell-cycle regulation; Lys-29-linked is involved in lysosomal degradation; Lys-33-linked is involved in kinase modification; Lys-48-linked is involved in protein degradation via the proteasome; Lys-63-linked is involved in endocytosis, DNA-damage responses as well as in signaling processes leading to activation of the transcription factor NF-kappa-B. Linear polymer chains formed via attachment by the initiator Met lead to cell signaling. Ubiquitin is usually conjugated to Lys residues of target proteins, however, in rare cases, conjugation to Cys or Ser residues has been observed. When polyubiquitin is free (unanchored-polyubiquitin), it also has distinct roles, such as in activation of protein kinases, and in signaling.
标记抗体
暂无标记数据
同靶标产品
暂无同靶标产品
相关文献
提示: 发表研究结果有使用 bsm-63008R 时请让我们知道,以便我们可以引用参考文章。作为回馈,资料提供者将获得我们送上的小礼品。
暂无相关文献
常见问题
暂无常见问题